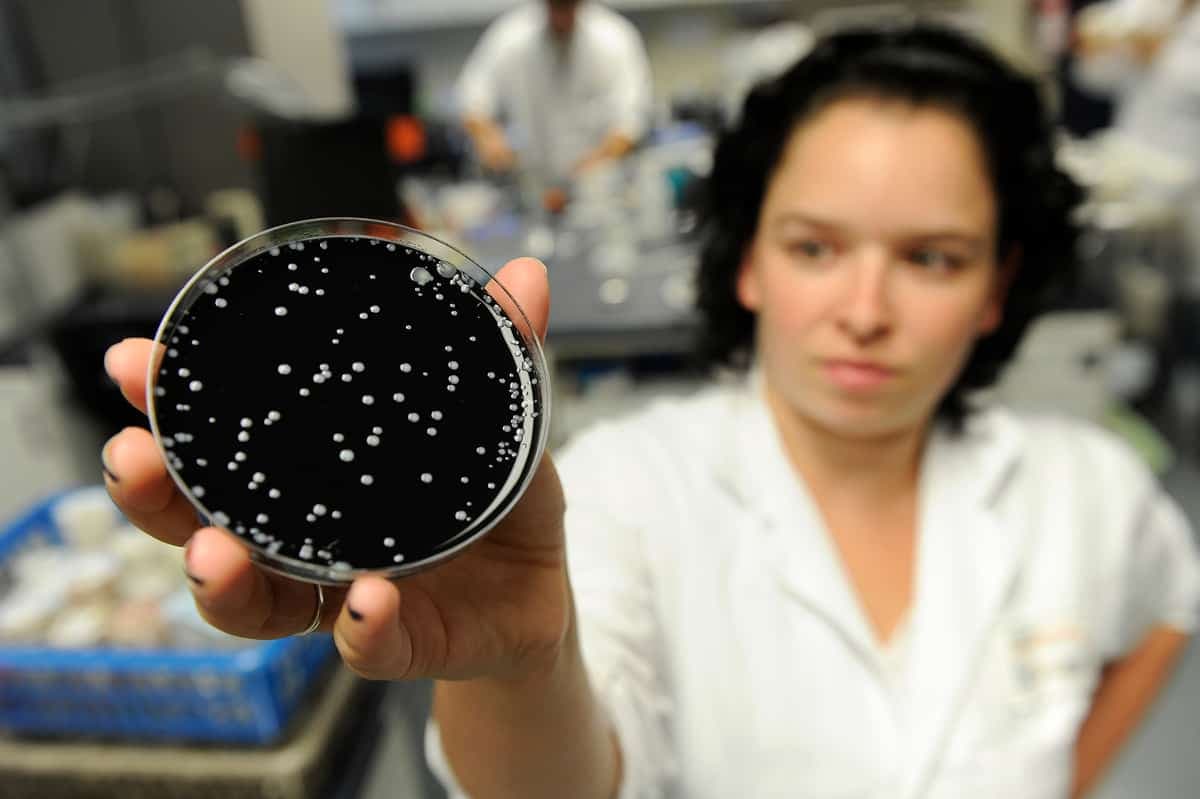

Les cas de légionellose pourraient augmenter à cause des changements climatiques, particulièrement à Montréal

Élizabeth Ménard
Le réchauffement climatique pourrait entraîner une augmentation des cas de légionellose à Montréal, une maladie infectieuse grave qui peut entrainer la mort, prévient un expert en santé publique.
Quelques dizaines de cas de légionellose sont déclarés chaque année à Montréal. Mais ce nombre pourrait bien augmenter dans les prochaines années, prévient le chef médical de l’équipe Environnements urbains et santé des populations à la Direction de la santé publique de Montréal, le Dr. David Kaiser.
«C'est quelque chose qu'on surveille de très près parce qu'on pourrait avoir quelque chose de très majeur dans notre contexte, compte tenu de la proximité des sources et des populations», dit-il.
Les tours de refroidissement à l’eau, généralement situées sur le toit d’immeubles, offrent l’environnement parfait pour la prolifération de la bactérie Legionella, à l’origine de la maladie légionellose, explique-t-il.
«Ce sont des tours qui font circuler l’eau et refroidissent les bâtiments. Mais ces tours-là génèrent des aérosols. Donc quand l’eau est contaminée, c’est très efficace pour contaminer l’environnement. Ça émet comme un panache de bactéries et ça fait que, quand tu passes devant le bâtiment, et même ça peut être à quelques kilomètres dans le quartier, tu peux être contaminé», dit-il.
Un risque accru à Montréal
Dans une ville comme Montréal, ces tours se comptent par centaines, voire milliers.
« Ce qu'on s'attend, avec le réchauffement à venir, c'est qu'elles soient en fonction plus longtemps parce que les étés vont être plus longs. On a aussi plus de risque parce que l'eau est plus chaude, plus longtemps», souligne Dr. Kaiser.
En France, on a déjà noté une augmentation de 31% des cas entre 2017 et 2018. Le réchauffement climatique est pointé du doigt.
« Une humidité importante, des températures élevées et de fortes précipitations. En juin 2018, la réunion de ces trois facteurs météorologiques a fait bondir de nombre de cas de légionellose en France», rapporte Europe1.
Une question d’entretien
À l’été 2012, 181 cas de Légionellose qui ont entraîné 13 décès sont survenus dans la ville de Québec, rappelle David Kaiser.
La contamination provenait d’une tour de la Place Jacques-Cartier, propriété de la Centrale des syndicats du Québec, qui avait été mal entretenue.
«On voit très bien qu'une tour non contrôlée peut générer beaucoup de dégâts rapidement. Dans des quartiers centraux, il y a beaucoup de tours et beaucoup de monde. Alors c'est un risque réel», fait-il valoir.
La prolifération de la bactérie dans les tours de refroidissement peut toutefois être facilement prévenue, soutient le docteur.
Il suffit de bien nettoyer le système et de faire régulièrement des tests de qualité de l’eau.